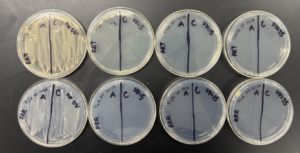
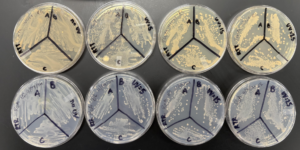

(4) RRR/T & RTR/R XIN Results
Riya D -
This week’s results really threw me for a loop!
Hypotheses: Since both trials have R2 (the low nutrient media) in that pre-UV stage, I think that the bacteria will have less energy to maintain their DNA repair mechanisms and will thus yield little to no radiation resistance under all UV levels (5, 15, and 25 mW/cm2).
RRR/T
- Procedure: Though I had inoculated 4 flasks with D. xinjiangensis, only two of the inoculations went through: Samples A and C. So, this trial only had biological duplicates.
- Results:
- Analysis: Concurrent with my hypothesis, these D. xinjiangensis had no growth under any of the UV levels! There was a little growth on the sample A section plated on R2A at a UV level of 25, but it was gram stained and found to be contamination, not D. xinjiangensis.
RTR/T
- Procedure: Since this trial had different media in the pre- and during-UV stages, I had to perform a triple wash. To do so, I spun down each of the samples after taking the OD and immediately resuspended them in PCR water. I did that twice. Then, for the last wash, I resuspended them in TGYB before exposing them to UV.
- Results:
- Analysis: Surprisingly, all the plates had growth, thereby refuting my hypothesis! And, it doesn’t even look as though the growth was diminished too harshly as the UV level increased.
As this week showed, it appears that it is in fact that during-UV stage that matters the most when it comes to D. xinjiangensis’s resistance: when the bacteria is exposed under TGY, they are quite resistant, yet when they are under R2, their resistance greatly diminishes.
Next week, I look forward to conducting that last trial, TRT/R, to confirm this new hypothesis!

Comments:
All viewpoints are welcome but profane, threatening, disrespectful, or harassing comments will not be tolerated and are subject to moderation up to, and including, full deletion.